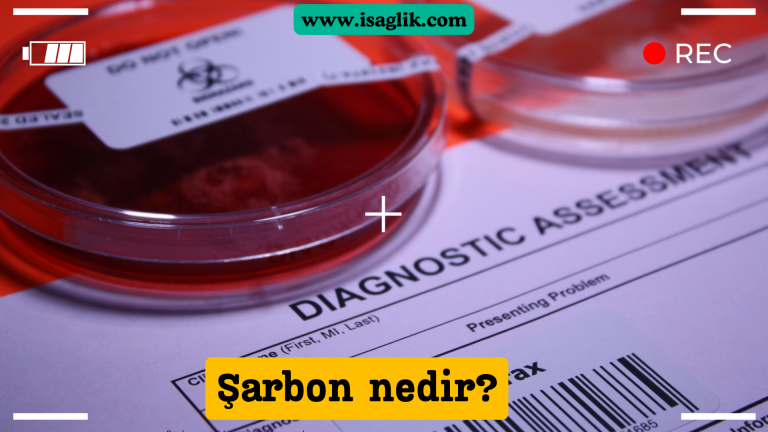
Şarbon, Bacillus anthracis adı verilen bir bakterinin neden olduğu ciddi bir enfeksiyon hastalığıdır. Hem insanlarda hem de hayvanlarda görülebilir ve genellikle ciddi olabilen bir zoonotik hastalıktır.

Şarbon nedir? Nasıl bulaşır? Belirtileri ve tedavisi
Şarbon: Bilgi ve Önlem Alınması Gereken Ciddi Bir Bakteriyel Hastalık Şarbon, Bacillus anthracis adı verilen bir bakterinin neden olduğu ciddi bir enfeksiyon hastalığıdır. Hem insanlarda hem de hayvanlarda görülebilir ve genellikle ciddi olabilen bir zoonotik hastalıktır. Bulaşma Yolları ve Risk…





